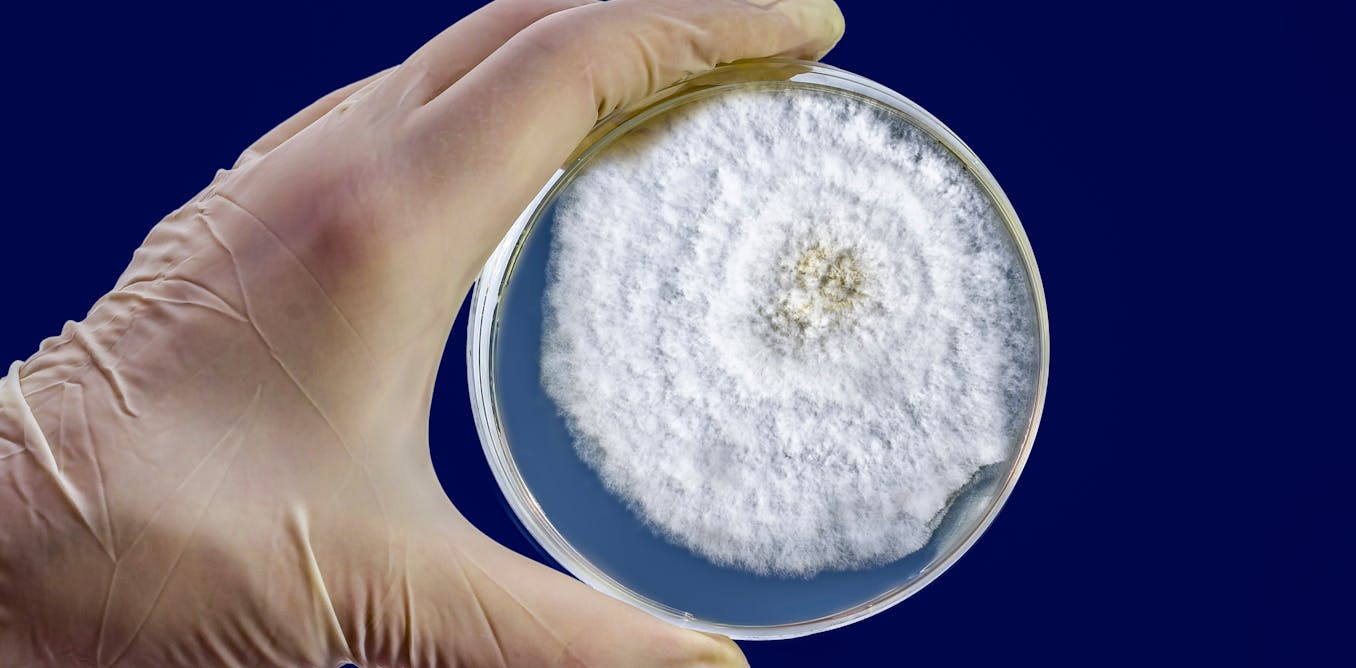

CEO Picks - The best that international journalism has to offer!
 S22 S22'Beyond The Spider-Verse' Might Erase the Franchise's Most Intriguing Villain   Miles Morales is a long way from home in Spider-Man: Across the Spider-Verse. In a shocking twist, Brooklyn’s one and only wallcrawler is transported to a universe that’s not his own, Earth-42. There, he comes face to face with himself: Miles G. Morales. In this timeline, Miles was never bitten by a radioactive spider, and thus never became Spider-Man. Instead, he followed in his uncle’s footsteps to become the Prowler, a development that will spell real trouble for our Miles in Spider-Man: Beyond the Spider-Verse.Aside from the threads set up in Across’ cliffhanger ending, not much is known about the plot of Beyond the Spider-Verse. Miles is trapped in Earth-42, while Gwen Stacy, Peter B. Parker, and his other friends are launching a rescue mission to bring him home. Miles is also racing against time to save his father from an imminent demise, which also happens to be a canon event: an experience that cannot be prevented without tearing apart the very fabric of time and space.
Continued here
|
 S1 S1 To Adapt During Crisis, Take a Lesson From Jazz   The winter 2024 issue features a special report on sustainability, and provides insights on developing leadership skills, recognizing and addressing caste discrimination, and engaging in strategic planning and execution.The winter 2024 issue features a special report on sustainability, and provides insights on developing leadership skills, recognizing and addressing caste discrimination, and engaging in strategic planning and execution.Crises, whether supply chain disruptions, natural disasters, or the arrival of an upstart rival, are a revealing moment for leaders. Such scenarios can push companies to the brink of meltdown or usher in dramatic organizational transformation. Whether an organization withers or thrives during a crisis is shaped by its resourcefulness — how it uses its existing resources.
Continued here
|
 S2 S2Do mocktails scratch the Dry January itch?   For Chicago comedian Kristi Durkin, 1 January ushered in a wave of new year's excitement – and a 31-day alcohol-free challenge. "Everyone on the internet is going sober," jokes Durkin. "Everyone is drinking, like, tart cherry juice, and I'm really susceptible to internet trends."Durkin, 26, has latched onto Dry January, an annual challenge popularised by advocacy group Alcohol Change UK. Each January, participants commit to a month without alcohol, ostensibly to "dry out" after the holidays, and explore the merits of a sober lifestyle
Continued here
|
 S3 S3Tilgul: A Indian sweet that encourages kind words   My cousin handed me a fistful of a tilgul, a simple gul (jaggery) and sesame sweet made with ghee (clarified butter), whispering words that everyone should carry with them at all times of the year: "tilgul ghya, goad-goad bola" ("take this sweet, speak good and kind words"). The words, a mantra for joyful and kind-hearted living, are typically spoken as people exchange the treatin the western state of Maharashtra to mark Makar Sankranti, an Indian holiday on 14-15 January that honours the year's end and a new beginning.As children, my cousins and I grabbed chunks of the tilgul – available as ladoo (round sweets), papdi (brittle), barfi (fudge), revdi (coin-sized treats), gajak (bars) and other forms – as we beelined for the door to the yard to resume playtime. The significance of the words was lost on us at that time; today, as mums ourselves, we realise the importance and implication of exhorting kindness and goodness in a world that can be unbearably hard and hostile.
Continued here
|
 S4 S4In re-electing its government, Taiwan has kept the status quo, but the victory hides a transformed political landscape   After months of intense campaigning, the Democratic Progressive Party (DPP) emerged victorious in the 2024 Taiwan presidential election, securing an historic third consecutive term. However, the party’s dominance has gone from absolute to relative; it secured only 40% of the presidential votes, and fell short of retaining the majority of legislative seats. Meanwhile, the Kuomintang (KMT) failed to retake the presidency as well as the majority of legislative seats. The remaining seats are held by Taiwan People’s Party (TPP).
Continued here
|
 S5 S5Urban Kenyans mistrust police even more than rural residents do: study sets out why it matters   Across the African continent – from Nigeria and Ghana to South Africa – widespread protests have taken place to demand police reform in the wake of police misconduct and brutality. A continent-wide survey done in 2022 shows very low trust in the police and a prevailing perception of the police as the most corrupt among key institutions.Low public trust in police poses a serious problem for the most central state institution tasked with upholding law and order. Trust influences both police effectiveness and the perception of safety among the public.
Continued here
|
 S6 S6
 S7 S7Don't count Biden out: January polls are historically unreliable   As 2024 begins, Joe Biden’s hopes of being re-elected president of the United States look shaky. Recent approval ratings have him at 39 per cent, consumer sentiment on the economy sits near a 10-year low and early polls have him down about two points in a hypothetical rematch with Donald Trump. First, in seven of the last eight presidential elections, the Democrat has won more votes. The Electoral College aside, American voters lean Democratic.
Continued here
|
 S8 S8Canadian schools need to address digital sexual violence in their curricula and policies   Technology-facilitated sexual violence (TFSV) is on the rise among Canadian youth. In an international study that included Canada, over half of the young women and girls surveyed reported being sexually threatened and/or sexually harassed online. This kind of sexual violence can include online sexual harassment, extortion, receiving unsolicited explicit images and non-consensual distribution of intimate images.More than four in five undergraduate students in Canada have reported experiencing online sexual violence, including sexually explicit comments, emails or messages.
Continued here
|
 S9 S9How to strengthen community resilience in a world plagued by crises   Rural communities are especially vulnerable to the impacts of climate change, a new federal report has found, because they often have fewer resources to handle environmental or social disruptions. While these communities may be innovative, they often lack access to the resources that broad networks, connections and collaboration can bring. Their focus on addressing immediate issues often depletes any existing resources, which limits their ability to build connections and networks.
Continued here
|
 S10 S10Canada should not fall behind on implementing safety measures for children online   Public Scholar & PhD Candidate, Electrical and Computer Engineering, Concordia University Recent legislation about age verification for adult content sites has sparked an interesting scenario in the Canadian parliament. On Dec. 13, Bill S-210, An Act to restrict young persons’ online access to sexually explicit material, passed the second reading in the House of Commons with a vote of 189 to 133.
Continued here
|
 S11 S11 S12 S12More than 4 billion people are eligible to vote in an election in 2024. Is this democracy's biggest test?   2024 is going to be democracy’s biggest year ever. In a remarkable milestone in human history, over four billion people – more than half of the world’s population across more than 40 countries – will go to the polls.National elections will be held in the United States, India, Indonesia, Russia, the United Kingdom, Pakistan, Bangladesh, Taiwan, Mexico, and South Africa to name just a few. The European Union will also go to the polls. This busy calendar of elections is as extraordinary for the diversity of nations and peoples participating as it is for its huge scale.
Continued here
|
 S13 S13The first Mickey Mouse is now in the public domain. How can I use the Disney character?   The earliest versions of Mickey and Minnie Mouse entered the public domain in the United States at the start of this year, 95 years since they were introduced to the public in the film Steamboat Willie. Many characters come into the public domain on New Year’s Day (Public Domain Day) every year. For works “made for hire”, including films, copyright in the United States lasts 95 years; for other works it is the life of an author plus 70 years.
Continued here
|
 S14 S14Help, I've just discovered my teen has watched porn! What should I do?   Unlike in previous generations, you’re unlikely to discover your adolescent’s first exposure to adult sexual content from finding a scrunched-up Playboy magazine under their mattress. With easy access to the internet and the use of tablets and mobile phones, it’s more likely to be from free, mainstream online porn. And it can be a very shocking introduction to sex.
Continued here
|
 S15 S15Do they see what we see? Bees and wasps join humans in being tricked by illusions of quantity   If you’ve ever been tricked by a visual illusion, you know the feeling of disconnect between what your eyes perceive and what is actually there. Visual illusions occur due to errors in our perception, causing us to misperceive certain characteristics of objects or scenes.As it turns out, many non-human animals also experience these effects, including illusions of item size, brightness, colour, shape, orientation, motion or quantity. We study these illusions and the differences between animals as it can tell us how visual systems evolved.
Continued here
|
 S16 S16 S17 S17As the billionaires gather at Davos, it's worth examining what's become of their dreams   Gathering for their annual World Economic Forum at Davos in Switzerland this week, the world’s business and political elite will be digesting some unpleasant reading courtesy of the aid agency Oxfam International. Oxfam’s annual report on global inequality released this morning shows the wealth of the world’s five richest billionaires has more than doubled since the start of the decade, while 60% of humanity has grown poorer.
Continued here
|
 S18 S18 S19 S19 S20 S20 S21 S21The Thomas Edison of Bedding   Los Angeles is lousy with pitches—unsolicited ideas proffered in elevators, at buffet spreads, while waiting for the barista to brew a chagaccino. In recent years, friends of Lee Eisenberg, an Emmy-nominated writer (“The Office”) and creator (“Jury Duty”), had been worn down by his spiels on his latest project—a new kind of duvet cover. No more wrestling unruly comforters into floppy, restrictive sleeves with elusive corners, Eisenberg promised. Heads nodded, but eyes rolled, too. “Everyone acknowledged there was a problem,” he recalled recently. “I don’t know that anyone acknowledged I was the person to fix it.”Eisenberg has now sold hundreds of told-you-so’s, at almost two hundred bucks a pop. While traditional duvet covers open on one side, requiring a bed-maker to awkwardly slide a comforter through a single entry slot, Eisenberg’s Nuvet unzips on three sides. He likens the situation with traditional duvet-cover design to “having two pieces of bread and trying to smush the meat in, or the tomatoes.” He pressed his palms together horizontally to illustrate. “That’s a really stupid way of making a sandwich.” The Nuvet, he said, is open-faced.
Continued here
|
 S23 S23Einstein's "Greatest Mistake" Could Actually Help Explain Why the Universe Is Expanding So Quickly   Dark energy may be a hypothetical vacuum energy first proposed by Einstein — or it may be something stranger and more complicated that changes over time.For the past quarter of a century, scientists have believed “normal” stuff like atoms and molecules that make up you, me, Earth, and nearly everything we can see only accounts for 5 percent of the universe. Another 25 percent is “dark matter,” an unknown substance we can’t see but which we can detect through how it affects normal matter via gravity.
Continued here
|
 S24 S247 Years Ago, an Overlooked Crime Thriller Planted the Seeds for 2024's Best Noir   This Sunday, True Detective makes its highly anticipated comeback with a thrilling season that looks to bring the crime anthology back to its glory days. But it would take more than the star power of Jodie Foster and a frigid new setting to reinvigorate a show that had long lost its luster as one of the biggest TV phenomenons of the past decade. Those play a part, for sure, but there’s a more significant factor at play: the deft direction of showrunner Issa López, who draws from the best classic horror movies to transform True Detective into a full-fledged supernatural thriller.It’s a genre López is intimately familiar with, having made a splash a little less than a decade ago with her eerie horror film Tigers Are Not Afraid. The 2017 crime fantasy-horror at first seems to have little in common with the new Alaska-set season of True Detective. Set in a Mexican city devastated by the cartels, Tigers Are Not Afraid follows Estrella (Paola Lara), a young girl orphaned by the gang that rules her town. She soon joins up with a group of fellow orphans who survive by looting empty houses and bonding over fairytales of princes who turn into tigers. But it's in the movie’s ghostly flairs that you can see López honing what she would perfect in True Detective: The Night Country.
Continued here
|
 S25 S2510 Years Later, the Most Underrated RPG Series Still Deserves Your Attention   We’re never satisfied with perfection. Perfect things are rarely given more than a moment to exist. They’re almost always seen as “the right thing at the right time.” Perfection is never allowed much staying power because we expect iteration and improvement, especially for something as commercial as gaming. There’s always room for more pixels, better lighting, or bigger maps. But every once in a while though, something perfect and timeless comes along. The first game in the series, The Banner Saga, arrived on January 14, 2014. Developed by Stoic Studio, a small team mostly made up of former BioWare employees, it began with a Kickstarter campaign. More than 20,000 backers raised $723,000, far surpassing their goal of $100k. It’s easy to see why it was successful: stunning visuals that invoke the work of Disney legend Eyvind Earle, a Norse-inspired setting, and a gameplay balance that’s a mix of XCOM, Dragon Age, and Oregon Trail.
Continued here
|
 S26 S265 Years Later, Marvel Finally Reverses Its Dumbest Mistake   For years, Marvel’s street-level collaboration with Netflix — which sired five mature, grungy shows and an Avengers-esque crossover — has been relegated to the far-flung corners of the franchise. The Defenders-verse, as it’s affectionately titled, walks a dubious line between canon and legend... even though it’s often regarded as one of the most successful products of the MCU. The subfranchise thrived on Netflix for four years, offering a grungy, adult-focused alternative to Marvel’s frictionless efforts on the big screen. But when Disney and Marvel turned their gaze to streaming, the Defenders suddenly became defunct. Marvel launched a new crop of shows on Disney+, ending its partnership with Netflix by pulling their shows from the platform, and altogether ignoring the Defenders’ impact on the multiverse.
Continued here
|
 S27 S27The First Big Thriller of 2024 Reveals the Power of an Overlooked Genre   The suburbs are supposed to be perfect neighborhoods devoid of the claustrophobia and urban grime of the cities they surround. They have two-story houses, green lawns, no violence or crime. They are, on the surface, peaceful pockets of domestic perfection. But there’s no such thing as perfection in our world, and that’s where Suburban Horror comes in.For nearly 50 years, the subgenre has posited that Suburban America is no freer from the world’s dangers than the cities and farmlands its communities were constructed as an escape from. Some horror films have argued there are great evils lurking beneath the surface of America’s suburbs, an idea partially rooted in the fact that the expansion and construction of many American suburbs was born from the white flight phenomenon of the 1950s and ’60s. Other horror films have delighted in disrupting the peacefulness of suburbia by brutally invading it.
Continued here
|
 S28 S28 S29 S29The 7 Most Important AI Gadgets You Need to Know About   In the 2010s, it seemed like everyone needed to make a smartphone. The iPhone was ascendant, Samsung made Android a household name, and it seemed like mobile-first everything was the only way forward. It was that mentality that produced disasters like the Amazon Fire Phone.In 2024, AI is everything, and after spending the last year finding places to put generative AI features across the world’s most popular apps, companies are now turning to physical hardware to see what dedicated sensors can do for the burgeoning AI models. Generative AI is far from perfect, but it feels like one of the surefire ways consumer technology can become interesting again.
Continued here
|
 S30 S30 S31 S31If You're Cheap But Want A Nicer Home, You'll Love These 50 Things   If you want to make your home nicer but you’re worried it’s going to be too expensive, check out the 50 products below: They’ll seriously upgrade various spaces around your home, starting at just $8. From problem-solving items like an absorbent coffee station mat to aesthetic picks like an adjustable planter that can hang from the ceiling or wall, everything has high-end vibes with budget-friendly prices.Most night-lights are bulky and ugly, but these LED night-lights feature a chic design and they don’t block the other outlet when plugged in. The brightness is adjustable and the lights will turn automatically at dusk. Each of the two lights has a lifespan of 30,000 hours.
Continued here
|
 S32 S32Are Candles Carcinogenic? Here's the Tough Truth   Post-holiday season, it’s likely you’ve accumulated some scented candles, some of which you just might regift to an acquaintance. But for all the cozy vibes and redolent scents candles offer, are they bad for our health? After all, they do involve active combustion and a release of fragrance molecules — all in an enclosed space. Here’s the lowdown on candles, health, and longevity.Technically, candles fall under the umbrella of air pollutants, emitting two types of adulterants. One is called particulate matter (PM), which comprises all airborne, breathable particles like soot. Of particular interest is PM2.5, meaning each particle is less than 2.5 micrometers in diameter. These minute pollutants are so small that once inhaled, they can embed themselves deep within your organs, contributing to inflammation.
Continued here
|
 S33 S33The Smartest Sci-Fi Show of 2023 Reveals a Brutal Truth About Space Exploration   Elon Musk claims he wants to help humanity settle Mars. What if he already had? In For All Mankind’s alternate timeline, the history of spaceflight in the 1990s and 2000s is utterly redefined by an independent space agency known as Helios. The parallels to SpaceX and Blue Origin are clear: a billionaire creates a vision for space exploration based on profit and supposed idealism. And although he’s very much not Elon Musk, Dev Ayesa — played by X-Men legend Edi Gathegi — is a pivotal and controversial figure in this parallel and somewhat better timeline.Everything that happens in the For All Mankind Season 4 finale is because of Dev, and he’s the last character we see when the show flashes forward to a new decade. Here’s why this morally duplicitous space mogul is both horribly realistic and a little aspirational. Spoilers head.
Continued here
|
 S34 S34Marvel Just Sank to an Embarrassing New Low   Until recently, the Marvel Cinematic Universe has always presented itself as a well-oiled machine that sucks up comics and spits out billion-dollar movies. But the truth is, many of the MCU’s biggest wins were the result of last-minute improvisation: especially when it comes to the franchise’s iconic post-credits scenes.The script for Nick Fury’s surprise appearance after the end of 2008’s Iron Man was written at the absolute last second, with comics scribe Brian Michael Bendis offering multiple dialogue options for the studio to choose from. And Thanos’ big reveal in The Avengers only happened because director Joss Whedon thought the character looked cool, with no foresight into how the Mad Titan would shape the MCU’s future. Of course, they can’t all be winners. Plenty of post-credits scenes introduce new characters or plotlines that never show up again. And yet, Marvel’s latest outing, Echo, represents a shocking new low for the post-credits scene as we know it.
Continued here
|
 S35 S35The grit of cacti and the drumbeat of time shape a sculptor's life philosophy | Aeon Videos   The German-born artist Klaus Rinke finds inspiration in and harmony with cacti. Indeed, these resourceful creatures, which grow slowly and – per Rinke – evoke the German soul with their prickly exteriors and soft interiors, surround his Venice, California studio. Evoking Rinke’s droll, absurdist sensibility, the short documentary The Cactus of Klaus (2023) takes viewers inside his perspective on life and art as framed by his decades-long cactus obsession. Through this construction, Rinke’s idiosyncratic worldview emerges – one that’s centred on vitality through creativity, and moored to the Earth and the steady drumbeat of time.
Continued here
|
 S36 S36Does language mirror the mind? An intellectual history | Aeon Essays   The ethnologist Frances Densmore, working for the Bureau of American Ethnology, and Mountain Chief, a Blackfoot leader. Photo from 1916. Courtesy the Library of CongressThe ethnologist Frances Densmore, working for the Bureau of American Ethnology, and Mountain Chief, a Blackfoot leader. Photo from 1916. Courtesy the Library of Congress
Continued here
|
 S37 S37Why strive? Stephen Fry reads Nick Cave's letter on the threat of computed creativity | Aeon Videos   In the events series Letters Live, performers read notable letters – old and new, original and written by others – in front of a live audience. In this video, as part of the Letters Live event at London’s Royal Albert Hall in November 2023, the British comedian and writer Stephen Fry reads a letter by the Australian musician Nick Cave on what Cave sees as ChatGPT’s potential to erode the human soul – with the AI chatbot presumably also standing in for any other generative AI systems that might replace human-created art. As Cave’s letter articulates how foregoing the struggle of creation risks destroying the ‘collective, essential and unconscious human spirit’, his characteristically masterful writing combined with Fry’s powerful reading serve as a reminder of the value and vitality of human creativity.
Continued here
|
 S38 S38 S39 S39 S40 S40 S41 S41 S42 S42 S43 S43 S44 S44 S45 S45 S46 S46 S47 S47The Taliban's curious love of SIM cards   A few months ago, Pakistan began forcibly deporting thousands of Afghans who had fled over the border when the Taliban returned to power in 2021. They returned to an Afghanistan engulfed by poverty, widespread starvation, and shortfalls in medicine and shelter. Upon arrival, the refugees found an unlikely welcome package: humanitarian aid, set up by the Taliban, in the form of food, tents, and free SIM cards.The SIM card detail caught my eye. It’s hard to believe now but a decade ago, Time magazine proclaimed that Afghanistan “is on the leading edge of a technology revolution.” Local telecom Roshan was feted by TechCrunch for “ending Afghan corruption, one text at a time.” I visited Kabul in 2012, six months after a cautiously triumphant President Barack Obama announced his intention to begin drawing down U.S. troops. The capital was full of smart young professionals who, despite enormous challenges, still believed in what digital technology could bring to a new, emergent Afghanistan.
Continued here
|
 S48 S48What SoundCloud Created Can Never Die   Kaytranada and Kehlani. Lil Nas X’s “Old Town Road.” Sheck Wes’ “Mo Bamba.” The commonalities these artists and songs share is neither region nor genre but platform. SoundCloud was their origin point. “It sparked so many careers once upon a time,” says Stonie Blue, a New York-based DJ and cofounder of BIYDIY Records. “Artists could upload their music straight to the community that would lurk there before the main focus was streaming on Apple Music or Spotify.” Since joining the platform in 2012, he was introduced to newbie artists like Sango, Dream Koala, Yeek, and WOLFE de MÇHLS. “SoundCloud,” he says, “always felt like the underground.”The element of discovery has been SoundCloud’s secret sauce since it launched in 2007. The Berlin-founded company has maintained its relevance by embracing a simple ethos: come as you are. That’s made SoundCloud the for-everybody platform—one that embraces all genres, sexualities, religions, and definitions of music and art. By setting itself up as a hub for community-oriented music streaming, it’s become a kind of incubator for avant-garde sounds. SoundCloud is everybody’s underground.
Continued here
|
 S49 S49Unpicking the Mystery of the Body's 'Second Brain'  ![]() From the moment you swallow a bite of food to the moment it exits your body, the gut is toiling to process this strange outside material. It has to break chunks down into small bits. It must distinguish healthy nutrients from toxins or pathogens and absorb only what is beneficial. And it does all this while moving the partially processed food one way through different factories of digestionâmouth, esophagus, stomach, through the intestines and out."Digestion is required for survival," said Marissa Scavuzzo, a postdoctoral researcher at Case Western Reserve University in Ohio. "We do it every day, but also, if you really think about it, it sounds very foreign and alien."
Continued here
|
 S50 S50We test-drove BMW's life-sized remote-controlled car   We parked an SUV in Las Vegas. This doesn’t typically justify an entire article, but the thing is, we weren’t in the car. We were remotely controlling it from an operating station as it navigated to the parking spot.It was a demo of BMW’s new “valet parking” concept, which was featured at the company’s booth at this year’s CES.
Continued here
|
 S51 S51The 5 most interesting PC monitors from CES 2024   Each year, the Consumer Electronics show brings a ton of new computer monitor announcements, and it's often difficult to figure out what's worth paying attention to. When it comes to the most interesting models this year, there were two noteworthy themes.
Continued here
|
 S52 S52Poem for Falling Bodies   I practice calling up the past for reassurance. That events outlast themselves. That a day of no great personal gain or loss inscribes itself somewhere. The way I keep in my mind two snakes entwined and falling to my feet as I walked under an oak tree one July. The way I ran down the hill as if the snakes cared enough to chase me. The way that moment stalks me, its tongue flickering even now as I pass under certain boughs and fear or feel a thud of what’s not there, which twists around what is: the air, the leaves, the roots that weave in and out of the mud, serpentine and mingling with the past to make a rain of snakes forever possible. I need to believe that ordinary trees—from which no bodies fall— can leave an imprint, furrow my brain with their forgettable gray branches in the middle of winter, all the leaves having already dropped from them.
Continued here
|
 S53 S53Fox News Isn't a Kingmaker   As the 2024 Republican presidential field began to stir three years ago, Fox News tried to make Ron DeSantis happen. From the week of the 2020 election through February 2021, the network invited DeSantis to appear 113 times, or almost once a day, according to the Tampa Bay Times. In an email uncovered by that newspaper, one Fox producer gushed to a member of DeSantis’s staff, “We see him as the future of the party.”Maybe, but the future isn’t now. After that early burst of attention, the DeSantis bandwagon never got out of the garage. DeSantis’s national support crested at about 30 percent in early 2023 before slipping to less than half that figure. His presidential campaign will be lucky to survive beyond an expected pounding in tomorrow’s Iowa caucus and further humiliation in the New Hampshire primary. That has much to do with his charisma-free persona and his party’s devotion to Donald Trump, but it also reveals something about Fox’s vaunted power to shape Republican politics—namely, that it’s a myth.
Continued here
|
 S54 S54Two Jewish Writers, a Bottle of Whiskey, and a Post-October 7 Reality   One hundred days after Hamas’s attack, looking back at a candid and intense late-night talk with two prominent authors, Joshua Cohen and Ruby Namdar.Hamas’s attack on October 7 had the effect of stopping time. Many Israelis and concerned Jews I’ve spoken with describe a day that has not yet ended for them—a continuous nightmare from which they can’t wake, a reality compounded by the knowledge that so many of the kidnapped are still in captivity. The fiercist critics of Israel’s actions over the past three months don’t want to hear, let alone acknowledge, these feelings, because the weeks of ongoing death and destruction in Gaza have erased for them the hours of rampant torture and rape and murder that preeceded them. Understandable though this reaction might be, it ignores the sense of rupture that many Jews now feel.
Continued here
|
 S55 S55The Painful Wait for Jonathan Franzen   This is an edition of The Atlantic Daily, a newsletter that guides you through the biggest stories of the day, helps you discover new ideas, and recommends the best in culture. Sign up for it here.Welcome back to The Daily’s Sunday culture edition, in which one Atlantic writer or editor reveals what’s keeping them entertained. Today’s special guest is Eleanor Barkhorn, a senior editor at The Atlantic who has edited stories about the value of sleepovers and why so many Americans have stopped going to church.
Continued here
|
 S56 S56Aaron Rodgers Is Lighting His Football Legacy on Fire   One of Aaron Rodgers’s biggest strengths as a Hall of Fame–caliber player is his awareness. At his best, the New York Jets quarterback can anticipate the movements of aggressive defenders and use his legs to create breathtaking plays down the field.If only Rodgers possessed such sharp awareness away from the football field, where he seems to have a knack for creating unnecessary drama and exposing himself as a fake intellectual who can’t seem to stop showcasing his rampant narcissism. He isn’t in danger of jeopardizing his inevitable entrance into the Hall of Fame, but the more he digs into these conspiracies and attempts to moonlight as an infectious-disease expert, the more his moves will overshadow his brilliant career.
Continued here
|
 S57 S57 S58 S58Yennayer: North Africa's 3,000-year-old new year's celebration   On the evening of 12 January, dozens of bonfires burned on the rocky hillside above the village of Tisselday in Morocco's High Atlas Mountains. They were lit by families for Yennayer, the Amazigh (or Berber) new year celebrations. The fires symbolise a cleansing or purification of the past year, explained Ahmed Agouni, a trained geologist and owner of the long-running Irocha guesthouse in his home village of Tisselday, some 1,530m above sea level on the High Atlas eastern slopes.The Amazigh calendar starts at 950 BCE, when King Sheshonq ascended the throne of Egypt, meaning this year is 2974. For Amazigh communities in Morocco, this Yennayer will be particularly special.
Continued here
|
 S59 S59Back to Black: Why the controversial Amy Winehouse biopic is angering fans   Just over a decade since the death of acclaimed singer-songwriter Amy Winehouse, a biopic promising to chart her "intense journey to fame" is already due for release. A new trailer for Back to Black released by StudioCanal and Monumental Pictures yesterday showed Industry breakout star Marisa Abela donning the singer's instantly recognisable 1960s-inspired beehive hairdo, heavy, winged eyeliner and swirling shoulder tattoos. But the reactions from Winehouse fans were far from positive: critics were quick to decry Winehouse's lack of autonomy over her representation in the film, accuse the film's producers of turning a profit from the singer's turbulent later years, and claim that the biopic comes too soon.More like this:- Back to Black: The millennial I Will Survive- The no.1 song that promoted safe sex- The extraordinary influence of Madonna
Continued here
|
 S60 S60Global deaths from fungal disease have doubled in a decade - new study   Principal Investigator, Manchester Fungal infection Group, University of Manchester Dr Denning and family hold Founder shares in F2G Ltd, a University of Manchester spin-out antifungal discovery company, and share options in TFF Pharma. He acts or has recently acted as a consultant to Pulmatrix, Pulmocide, Biosergen, TFF Pharmaceuticals, Rostra Therapeutics, Mucpharma PTY and Lifemine Therapeutics. In the last 3 years, he has been paid for talks on behalf of Mundipharma, BioRad, Basilea, Gilead, Avir and Pfizer. He has been involved in multiple guideline groups, primarily focussed on diagnostics and aspergillosis. He was the founder of Global Action For Fungal Infections in 2013, and was its unpaid Chief Executive until 2023.
Continued here
|
 S61 S61What enforcement power does the International Court of Justice have in South Africa's genocide case against Israel?   South Africa says that Israel is committing genocide against Palestinians in Gaza and has asked the International Court of Justice to intervene and stop Israeli military action in Gaza. Israel issued its initial defense to South Africa’s charges on Jan. 12, 2024, at the International Court of Justice – the United Nations’ highest human rights court – based in The Hague, Netherlands. Israel argues that its military is trying to minimize civilian harm and that South Africa is trying to both weaponize the term genocide and interfere with Israel’s right of self-defense against Hamas.
Continued here
|
 S62 S62Ethiopia's deal with Somaliland upends regional dynamics, risking strife across the Horn of Africa   The Horn of Africa ushered in the new year with news of a deal that would ensure that diplomatic relations in the region got off to a bumpy start in 2024. Ethiopia, it was announced on Jan. 1, had signed a memorandum of understanding with the breakaway region of Somaliland, opening the door to an agreement to exchange a stake in flagship carrier Ethiopian Airlines for access to the Gulf of Aden.Such transactions of economic reciprocity are generally routine, as scholars of international relations and law like myself are aware.
Continued here
|
 S63 S63The Deadly Challenges of War Coverage in Gaza   On December 12th, the CNN correspondent Clarissa Ward became the first Western reporter to enter Gaza without an I.D.F. escort since the war began. Crammed into the back seat of a car, she and her crew captured images of the bombed-out buildings and streets of Rafah, the southernmost city in Gaza which shares a border with Egypt. According to one recent U.N. estimate, eighty-five per cent of Gaza’s 2.3 million residents had fled there. Crowds milled outside a bakery, and parents walked hand in hand with their children past mountains of rubble. “The Israeli military says it has hit Gaza with more than twenty-two thousand strikes,” Ward said during the ride. “That by far surpasses anything we’ve seen in modern warfare in terms of intensity and ferocity, and we really, honestly, are just getting a glimpse of it here.”Since the start of the Israeli invasion, it has been largely Arab media that have provided the world with on-the-ground reporting from Gaza, where the death toll has surpassed an estimated twenty-three thousand in just three months. The coverage is often harrowing and raw. A recent live report from Rafah by the Al Jazeera reporter Hani Mahmoud captured what sounded like the whine of a plane overhead and several missiles hitting a group of buildings, one after the other, sending plumes of dense black smoke into the air. “Oh, my God,” Mahmoud can be heard saying after ducking out of the frame to take cover. “That’s the hospital!” According to a later Al Jazeera report, the strike did not hit the hospital but nearby residential buildings, killing at least ten people.
Continued here
|
 S64 S64The Cryptic Crossword: Sunday, January 14, 2024   By signing up, you agree to our User Agreement and Privacy Policy & Cookie Statement. This site is protected by reCAPTCHA and the Google Privacy Policy and Terms of Service apply.© 2024 Condé Nast. All rights reserved. Use of this site constitutes acceptance of our User Agreement and Privacy Policy and Cookie Statement and Your California Privacy Rights. The New Yorker may earn a portion of sales from products that are purchased through our site as part of our Affiliate Partnerships with retailers. The material on this site may not be reproduced, distributed, transmitted, cached or otherwise used, except with the prior written permission of Condé Nast. Ad Choices
Continued here
|
 S65 S65The MCU's Newest Hero Reveals the Real Purpose of Marvel's Phase 5   The Marvel Cinematic Universe has built its brand on planning years ahead and dividing its narrative into “Phases” and “Sagas.” But when that plan gets derailed, it can put the entire universe in jeopardy. Right in the middle of Phase 5, the second phase of the “Multiverse Saga,” all signs are pointing towards steering away from the multiverse altogether. But maybe Echo, Marvel’s latest release, has a theme that could salvage the direction of Phase 5 — and even the entire Multiverse Saga itself.
Continued here
|
 S66 S66A Mystery Involving How Plants Grow Could Revolutionize Farming If Solved   Plant roots pulsate, and we don’t know why, but the answer could transform the way we grow things. You probably don’t think about plant roots all that much — they’re hidden underground, after all. Yet they’re continually changing the shape of the world. This process happens in your garden, where plants use invisible mechanisms for their never-ending growth.
Continued here
|
 S67 S67Netflix Just Quietly Added the Most Important Action Thriller of the Century   There’s a new John Wick knockoff in theaters, but the original is still your best bet for a good time.Some movies are so good, they become a genre all their own. Take Diehard, which launched countless imitators in the mold of everyman hero John McClane (even as its sequels forgot he wasn’t actually a superhero). Or Sharknado, which inspired a wave of bizarre movie mashups. But when it comes to inspiring endless copycats that never quite measure up to the original, one movie stands alone — and it’s streaming now on Netflix.
Continued here
|
 S68 S6815 Years Ago, The Lord of the Rings Squandered the Perfect Video Game Idea   Licensed video games have always been a mixed bag, but a few have managed to stand out. Lord of the Rings is one of those franchises that just makes sense in games: an expansive fantasy saga brimming with potential. Peter Jackson’s films gave the franchise a fantastic visual language to use, especially when it came to the epic battles it represented so well. With that in mind, a video game focused on capturing those unforgettable battles is an incredible idea and something that, by all accounts, should have worked. Unfortunately, 15 years ago, Lord of the Rings: Conquest squandered the perfect chance to make an unforgettable experience.The biggest sin of Lord of the Rings: Conquest is that it’s overwhelming mediocre, an uninspired experience that isn’t objectively broken but simply doesn’t do anything with the fantastic source material. It’s especially frustrating because Conquest was developed by the now-defunct Pandemic Studios, the developer behind the beloved Star Wars Battlefront games. This was meant to be the Lord of the Rings version of Battlefront, which again, is a phenomenal idea on paper.
Continued here
|
 S69 S6945 Genius, Cheap Things That Make You Look & Feel 10X Better   For every inconvenient situation life might present, you can rest assured there’s something clever out there that can resolve the issue. No time to wash your hair? Worked out hard and are feeling some muscle soreness? There are things to help — and these things are often easy to use, inexpensive, and readily available. You just have to know about them. These genius finds on Amazon can help you look and feel 10 times better, from head to toe, inside and out.A good manicure always includes a cuticle cream because ratty cuticles mar the look of your hands. This Onsen cuticle cream deeply nourishes your nail bed with a powerful blend of Japanese seaweed, minerals, aloe, bran oil, shea butter, and vitamin E. All you do is apply it. It’s designed to stay put without dripping or making a mess.
Continued here
|
 S70 S7023 Years Later, Star Trek's Most Polarizing Show Didn't Break Canon As Much as Fans Think   John Billingsley is serious about the positive impact of Star Trek on the real world. But don’t get bogged down by the details.For four years, John Billingsley played Dr. Phlox, the resident physician and the first doctor on a Starfleet starship named “Enterprise.” From 2001 to 2005, the prequel series Star Trek: Enterprise took a long road, getting from there to here, and ultimately (and unfairly) became known as the last Trek series for a very long time.
Continued here
|
 |
TradeBriefs Publications are read by over 10,00,000 Industry Executives About Us | Advertise Privacy Policy Unsubscribe (one-click) You are receiving this mail because of your subscription with TradeBriefs.
Our mailing address is GF 25/39, West Patel Nagar, New Delhi 110008, India |